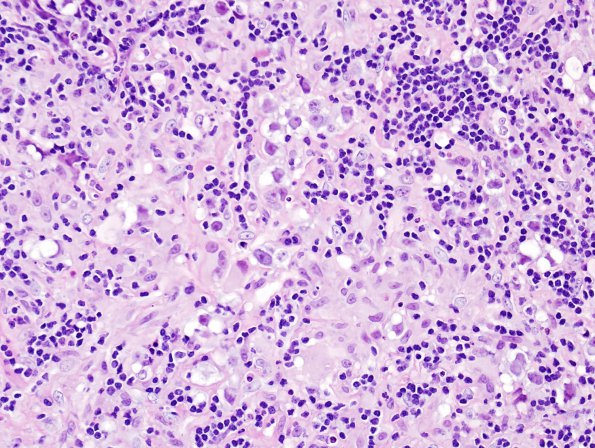
4B2 Germinoma (Case 4) granulomatous reaction 4

Table of Contents
Washington University Experience | NEOPLASMS (NON-GLIAL NON-NEURONAL) | Germ Cell Neoplasm - Germinoma | 4B2 Germinoma (Case 4) granulomatous reaction 4
4B2-4 These tumor cells are accompanied by a lymphocytic infiltrate. Delicate fibrovascular septae coarse throughout the tumor. Accompanying the neoplastic component is a dense well-formed granulomatous infiltrate which includes lymphocytes, epithelioid macrophages and multinucleated giant cells (arrows, 4B3,4).